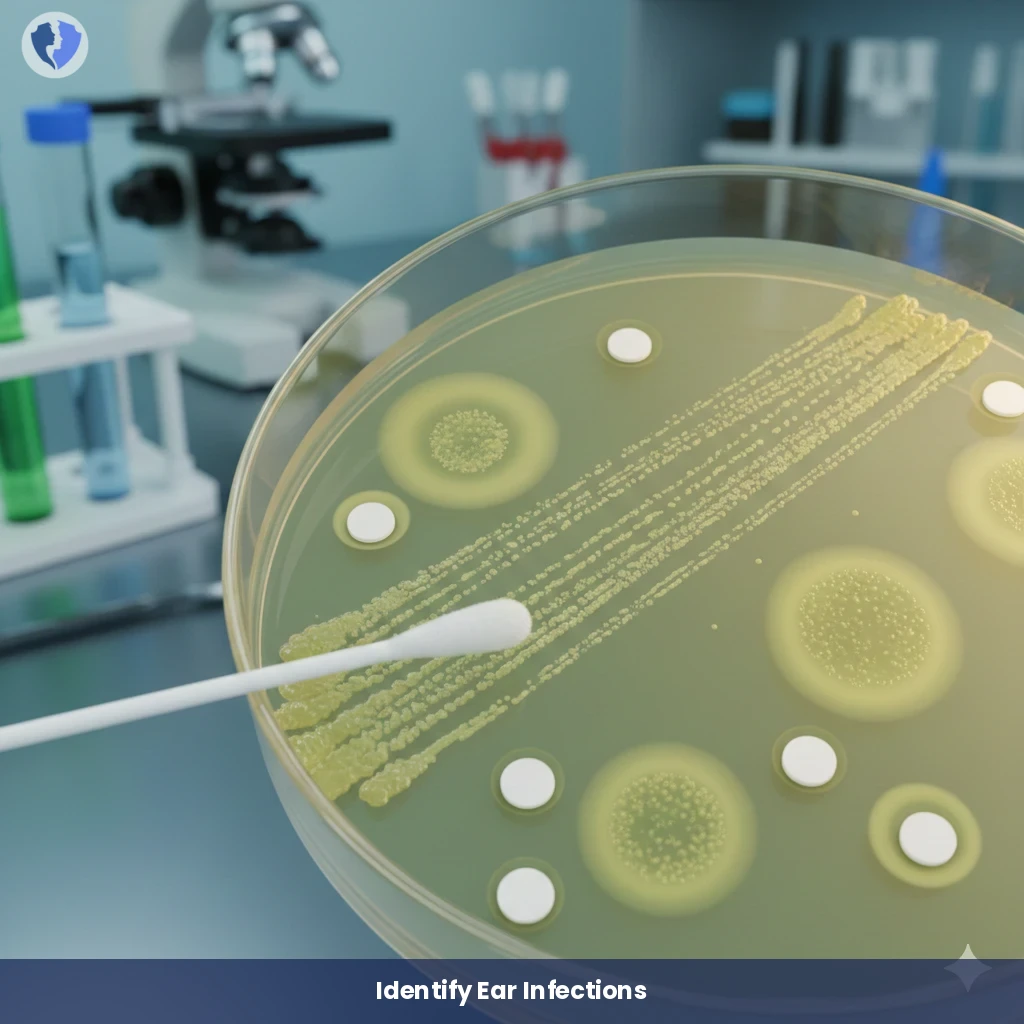
Comprehensive Ear Infection Test - Right Ear Discharge Culture and Sensitivity Test

Service Details
Comprehensive Ear Infection Test - Right Ear Discharge Culture and Sensitivity Test
A microbiological test in which a sample of right ear discharge is cultured on special growth media to identify the microorganisms (bacteria or fungi) causing the infection. The test also includes an antibiotic sensitivity test to determine the most effective antibiotics or antifungal agents against the identified microbial isolate.